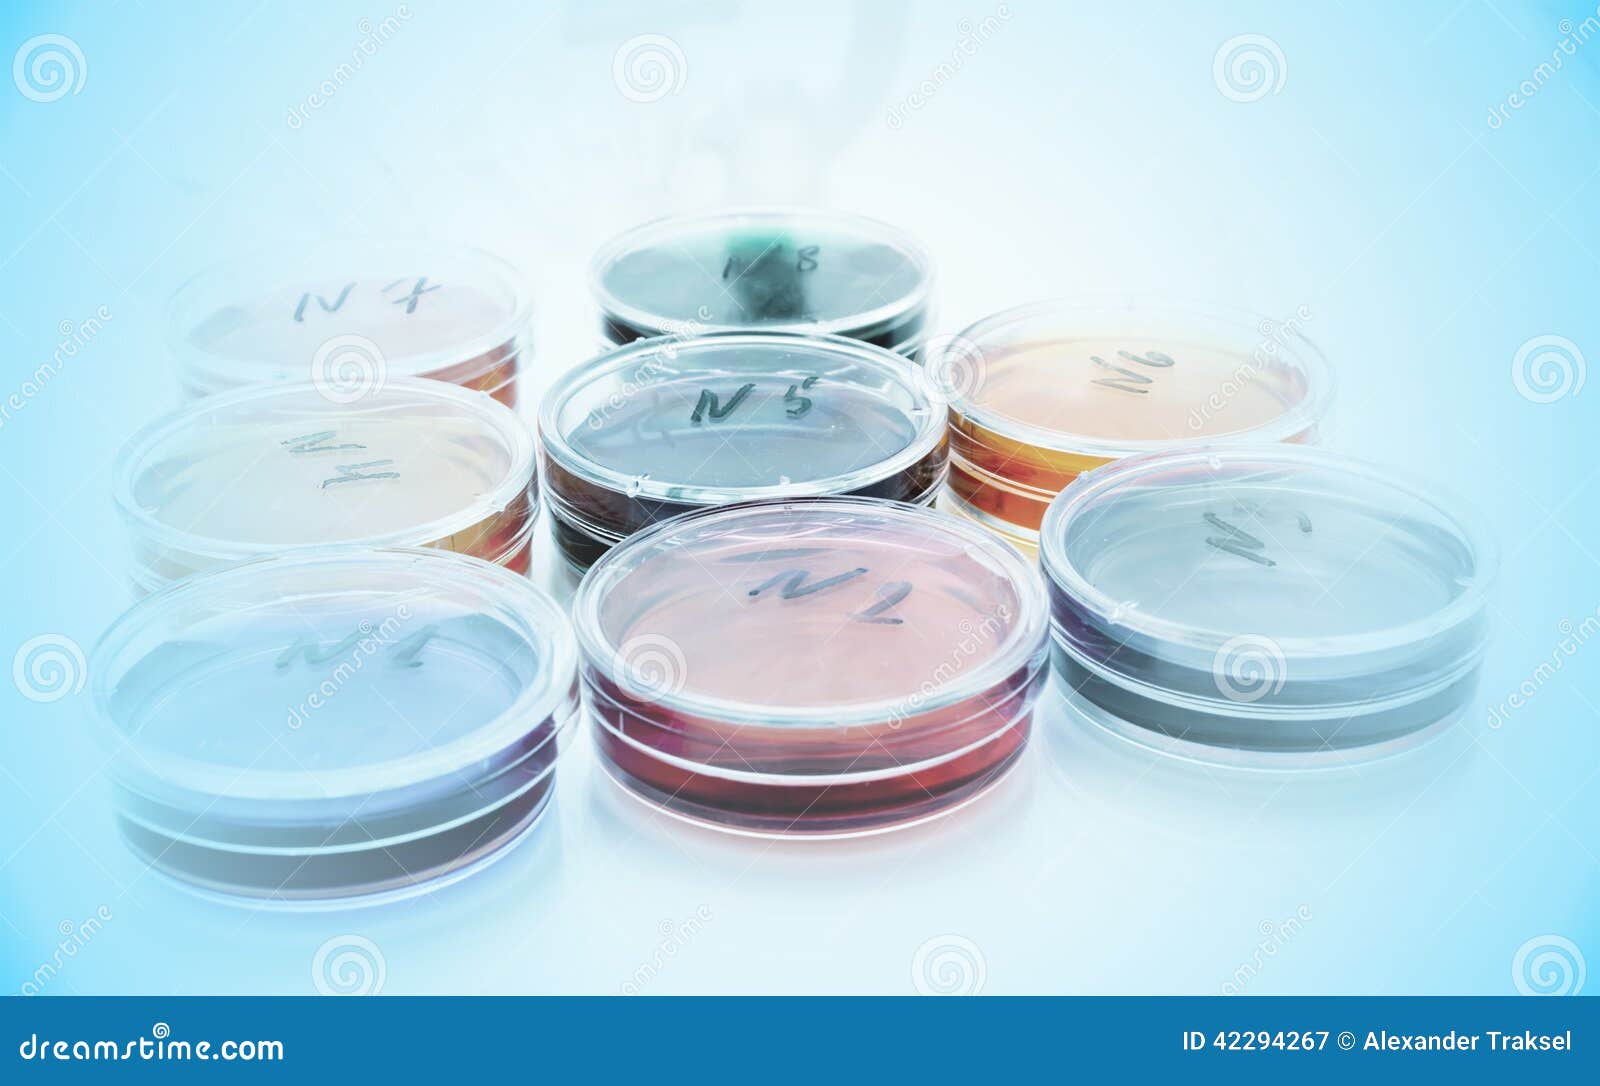

Rivenditore di plastica sterile e plastica varia, vetreria da laboratorio e strumentazione. Capsula di petri sterile in polistirolo quadrata, lato 1mm.
La piastra di Petri o capsula di Petri è un recipiente piatto di vetro o plastica, solitamente di forma cilindrica. Una capsula di Petri (detta anche: piatto, piastra, disco, scatola di Petri) è un piatto cilindrico di vetro o plastica coperto, usato dai biologi per le . Capsule di Petri da laboratorio sterili 120x20mm (pezzi): Amazon. STERLIN - Confezione da piastre di Petri in plastica usa e getta, diametro: mm, . Guarda la scheda ed i dettagli del prodotto Capsule di petri ø 1mm superficie.
Plastica per colture cellulari Capsule di Petri Capsule di Petri Ø 1mm . Gamma di piastre petri in varie dimensioni, ventilate e non,disponibili anche con griglia di conta.
Nessun commento:
Posta un commento